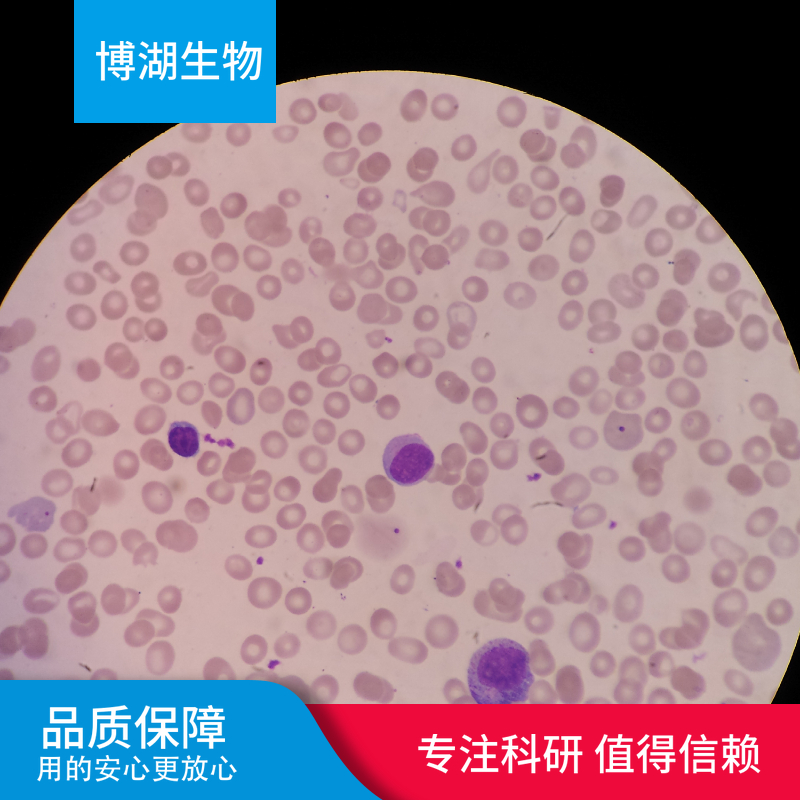
兔睾丸间质细胞

细胞简介:

兔睾丸间质细胞分离自睾丸组织;睾丸间质细胞成群分布在曲精小管之间,胞体呈圆形,椭圆形或不规则形,胞体较大,直径约20μm,胞质呈嗜酸性,细胞核呈圆形或卵圆形,常位于中央,染色较淡,有1-2个核仁线粒体多,呈管嵴状,无分泌颗粒。从青春期开始,睾丸间质细胞受垂体前叶嗜碱性细胞分泌的间质细胞刺激素(黄体生成素)的作用,能合成分泌雄性激素,可促进精子的发生和男性生殖器官发育,以及维持第二性征和性功能。
产品名称 | 兔睾丸间质细胞 | 产品货号 | P-X2127 |
英文名称 | Rabbit Testicular Mesenchymal Cells | 规格 | 5×10^5 |
报告 | 提供免疫荧光鉴定报告 | 组织来源 | 睾丸组织 |
产品信息:

方法简介:实验室分离的兔睾丸间质细胞采用胶原酶消化法制备而来,细胞总量约为5×10⁵cells/瓶。
质量检测:实验室分离的兔睾丸间质细胞经3β-HSD免疫荧光鉴定,纯度可达90%以上,且不含有HIV-1、HBV、HCV、支原体、细菌、酵母和真菌等。
产品名称:兔睾丸间质细胞
组织来源:睾丸组织
产品规格:5×10⁵Cells/T25培养瓶
培养信息:包被条件
培养基含FBS、生长添加剂、Penicillin、Streptomycin等
换液频率:每2-3天换液一次
生长特性:贴壁
细胞形态:成纤维细胞样
传代特性:可传5代左右;3代以内状态最佳
消化液:0.25%胰蛋白酶兔睾丸间质细胞体外培养周期有限;建议使用配套的专用生长培养基及正确的操作方法来培养,以此保证该细胞的最佳培养状态。
原代细胞实验主要应用领域:

基础医学与生命科学研究
细胞生理、信号通路、代谢、增殖 / 凋亡机制
干细胞分化、组织发育、再生生物学
神经科学:神经元、胶质细胞功能研究
疾病机制研究
肿瘤原代细胞:模拟患者真实肿瘤生物学行为
心血管疾病:内皮、平滑肌细胞功能
肝病、肾病、肺病、糖尿病等器官疾病模型
炎症、免疫反应:原代免疫细胞(巨噬细胞、T 细胞等)
药物研发与筛选
化合物细胞毒性、安全性评价
药效筛选、剂量反应、作用靶点验证
药代、药物转运、药物代谢研究
临床前个体化用药测试(如患者原代肿瘤细胞药敏试验)
临床检验与精准医疗
肿瘤药敏试验、化疗 / 靶向药疗效预测
免疫细胞功能检测
罕见病、遗传病的细胞模型建立
疫苗与生物制品
病毒分离、培养、滴度测定
疫苗效力、安全性评价
抗体、重组蛋白、细胞治疗产品研发
操作过程:

组织消化的细节:
分阶段消化:对于致密组织(如肾脏、乳腺),可先剪碎至1mm³左右的小块,用PBS清洗2-3次去除血液和杂质,再进行酶消化,避免杂质影响酶的活性。
间歇振荡消化:消化过程中可将培养瓶置于摇床上,以60-80rpm的速度轻微振荡,促进酶与组织充分接触,提高消化效率。
细胞计数与接种:
计数前混匀:细胞悬液需充分混匀后再取样计数,避免细胞沉降导致计数误差;计数时至少计数2个方格,取平均值提高准确性。
接种后静置:细胞接种后将培养瓶置于培养箱内静置2-4小时,期间不要晃动,让细胞自然贴壁,之后再轻轻更换培养位置。
换液与传代的技巧:
换液留底液:换液时不要完全倒掉旧培养基,可保留10%左右的底液,减少细胞环境的突变,帮助细胞适应新培养基。
传代避免过度消化:原代细胞对胰蛋白酶更敏感,传代时消化时间比传代细胞短2-3分钟,镜下观察到细胞边缘收缩、开始脱落时即可终止消化。
公司正在出售的产品:

小鼠杂交瘤细胞;D7C5E2 | 球孢子菌通用探针法荧光定量PCR试剂盒 |
小鼠杂交瘤细胞;IE3A10C8E5 | 嗜人锥蝇探针法荧光定量PCR试剂盒 |
小鼠杂交瘤细胞;IF4B7 | 脑多头囊虫探针法荧光定量PCR试剂盒 |
小鼠杂交瘤细胞;ID7 | 节状古柏线虫探针法荧光定量PCR试剂盒 |
小鼠杂交瘤细胞;2E8E9E10F2 | 猪链球菌通用PCR检测试剂盒 |
小鼠杂交瘤细胞;2F1-F6 | 败血梭状芽胞杆菌探针法荧光定量PCR试剂盒 |
小鼠杂交瘤细胞;2F1-D4-F6 | 索氏梭状芽孢杆菌探针法荧光定量PCR试剂盒 |
小鼠杂交瘤细胞;1H6 | 生孢梭菌(生孢梭状芽孢杆菌)探针法荧光定量PCR试剂盒 |
人Burkitt's淋巴瘤细胞;NAMALWA | 梭状芽孢杆菌属通用探针法荧光定量PCR试剂盒 |
小鼠杂交瘤细胞;1F3 | 破伤风梭状芽孢杆菌探针法荧光定量PCR试剂盒 |
小鼠杂交瘤细胞;IIB13 | 粗球孢子菌探针法荧光定量PCR试剂盒 |
小鼠杂交瘤细胞;IIIA3a | 波萨达斯球孢子菌探针法荧光定量PCR试剂盒 |
小鼠杂交瘤细胞;3D2 | 兔睾丸间质细胞鸽疱疹病毒1型探针法荧光定量PCR试剂盒 |
抗GST蛋白单抗杂交瘤细胞;4F10 | 传染性脓疱皮炎病毒探针法荧光定量PCR试剂盒 |
小鼠杂交瘤细胞;c7b8a3 | 短古柏线虫探针法荧光定量PCR试剂盒 |